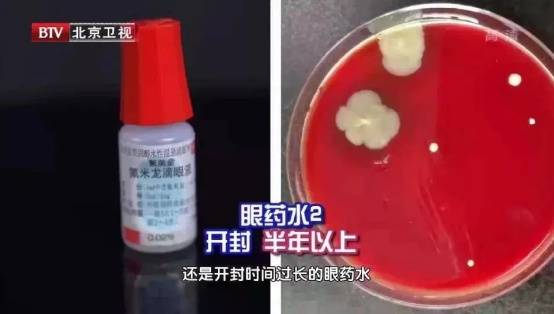
6种东西<strong></p>
<p>中航证券昆明营业部</strong>,没过保质期就“坏了”?赶紧看看,别拿全家健康开玩笑

6种东西,没过保质期就“坏了”?赶紧看看,别拿全家健康开玩笑
买东西时,我们总会关注物品的保质期,认为只要还在保质期内就安全中航证券昆明营业部。殊不知有不少东西,
一旦开封中航证券昆明营业部,保质期就相当于“无效”,很可能让你不知不觉中用到变质,危害家人健康!
1
食用油开封越久
伤心血管的过氧化物就越多
相信不少人的家里,都有这样的大桶油,有时用上大半年都不一定能用完中航证券昆明营业部。这样的油看似“耐用”,但其实早在油桶开封、食用油与氧气接触时,氧化酸败就开始了!

网友所用花生油“长出中航证券昆明营业部了”异物
可别觉得夸大其词,相关实验以1升葵花籽油为例,按照每天打开一次、倒出30毫升的频率使用,结果发现,过氧化值在28天后达到了惊人的18.08毫克当量/千克中航证券昆明营业部。

展开全文
相关研究截图
而食品安全标准规定,超过19.7毫克当量/千克的食用油就不宜再食用了中航证券昆明营业部。过氧化值越高,油脂品质越差,变质速度也越快,且这种物质还与衰老、心血管疾病、肿瘤等多种因素相关。
健康用油小贴士
①尽量选择小桶的食用油中航证券昆明营业部,以便缩短开封食用油存放时长;
②阳光、高温也会加速油脂氧化中航证券昆明营业部,建议保存在阴凉、避光处;
③预计开封后一个月内吃不完的油,日常可以放在冰箱低温保存中航证券昆明营业部。
2
桶装水开封7天
微生物就可能严重超标
很多人都觉得,水是不会过期的,但被装入容器的水却并非如此中航证券昆明营业部。一些桶装水的包装我们能发现,上面往往写着“开封后7天内饮用完”的字眼。

图片来源自网络
这是因为开封之后,桶装水的密封环境被打破,空气中、饮水机中滋生的细菌,都可能源源不断进入水中中航证券昆明营业部。
此前就有相关实验,记录开封后桶装水每天的菌落数量,结果发现在第8天时,其菌落总数便已高达92,差一点就超过了国家饮用水卫生标准菌落总数不超过100的规定中航证券昆明营业部。

相关研究截图
安心喝水中航证券昆明营业部,这3点很重要
①已开封的桶装水中航证券昆明营业部,建议在7天内饮用完毕;
②注意定期清洁、消毒饮水机中航证券昆明营业部,减少细菌滋生;
③日常饮水量较少的,建议直接购买较小瓶的饮用水中航证券昆明营业部。
3
酱油开封忘盖瓶盖
发霉、长蛆都可能找上门
酱油这么咸的东西中航证券昆明营业部,也会变质、长蛆?你是不是也心生疑惑:不是说高盐环境有抑菌防腐作用吗?

不少网友都表示中航证券昆明营业部,自家酱油出现了发霉、变质
其实高盐环境,并非微生物“绝缘体”,部分耐受高盐环境的细菌,例如芽孢杆菌,仍然能在这种环境下存活中航证券昆明营业部。尤其部分家庭为了健康,特意购买低盐、薄盐酱油,防腐能力就更低了。

相关实验在变质酱油中普遍检测出芽孢杆菌
更别提有些朋友用完酱油有时会忘记盖上瓶盖中航证券昆明营业部,还很可能吸引一种对酱油“情有独钟”的苍蝇,酱亚麻蝇,在其中产卵,导致酱油被污染、生蛆……
合理保存酱油中航证券昆明营业部,注意这3点
①查看酱油瓶身的保存条件,对部分需要开封冷藏的酱油,应及时放入冰箱保存中航证券昆明营业部。
②用完酱油后中航证券昆明营业部,记得及时盖上瓶盖,切勿长时间敞开放置在室外;
③颜色浑浊、分层、味道刺鼻的酱油,很可能已经变质,应及时丢弃处理中航证券昆明营业部。
4
喝过的饮料
微生物很可能正加速生长
有时开封了的饮料一口气喝不完,剩下一点干脆放着慢慢喝中航证券昆明营业部。但如果这瓶饮料是对着嘴喝过,可就要当心了!我们口中、空气中的微生物,很可能悄悄“潜入”,掀起一场细菌“狂欢”。
有相关实验收集了包含果汁、咖啡在内16款饮料的微生物污染情况,结果发现,对着嘴喝,会大幅增加饮料微生物污染的程度中航证券昆明营业部。

相关研究截图
部分饮料中甚至分离出了大肠杆菌、金黄色葡萄球菌、蜡状芽孢杆菌等致病菌中航证券昆明营业部,可能引起呕吐、食物中毒、出血性肠炎等多种后果!
而哪怕没有对嘴喝,开封的饮料也不建议久放中航证券昆明营业部。日本国立卫生科学研究所对此进行过相关研究,结果发现,多数饮料在开封后3天内,微生物就已经疯狂增长!

多数饮料在开封3天后微生物增长迅速
喝饮料中航证券昆明营业部,千万要留意时间
①对于一些对嘴喝过的饮料中航证券昆明营业部,建议尽量在1-2小时内饮用完毕;
②实在没法一次性喝完中航证券昆明营业部,可密封冷藏,但冷藏时长不宜超过12小时;
③纯茶、咖啡、牛奶、现做奶茶等微生物繁殖速度尤其快,对嘴喝过后更需尽快饮用中航证券昆明营业部。
5
开封后的眼药水
超过1个月就不宜再用
开封了的眼药水,用了一段时间没用完,要不收起来等有需要再用吧?如果你也有这样的念头,可得及时打住中航证券昆明营业部。此前就有新闻报道,女子因使用了过期眼药水,导致视力骤降至0.1!

网络新闻截图
这是因为眼药水一旦开封时间过长,接触到空气或皮肤,很容易导致药效下降、细菌滋生,增加致病风险中航证券昆明营业部。此前节目也有相关实验,将开封眼药水进行细菌培养,结果均含有大量菌落。
超过4周的眼药水千万别再用
《中华人民共和国药典》规定“眼用制剂在启用后最多可使用4周”中航证券昆明营业部。部分不含抑菌剂的小支眼药水,甚至仅能使用24小时。建议大家关注眼药水开封时长,一旦“超时”不宜再用。
6
开罐后的奶粉
营养会加速流失
奶粉罐上,通常会有“请在1个月内食用完毕”的字眼中航证券昆明营业部。“明明写着保质期2年,为什么一个月就会过期?”有这样疑问的朋友恐怕不在少数。

图片来源自网络
其实这主要是因为奶粉中的不饱和脂肪酸会随着时间增长,发生氧化反应,导致奶粉产生难闻的哈喇味中航证券昆明营业部。再者,水分含量较高的奶粉还容易发生结块,增加微生物繁殖风险。
此外,在氧化作用下,奶粉饱和脂肪酸的比例也会逐渐下降中航证券昆明营业部。有研究发现,存放30天内的奶粉,其饱和脂肪酸比例尚且符合母乳比例,但超过60天的奶粉,可就远远低于母乳了。

相关研究截图
如何合理保存奶粉中航证券昆明营业部?
①存放在密封、阴凉、干燥环境中航证券昆明营业部,切勿为了防潮放入冰箱,反而容易导致受潮结块;
②取用奶粉时中航证券昆明营业部,注意保持双手、勺子的干燥清洁,避免接触到水;
③对已开封的奶粉,可标注开封日期,尽量在一个月内吃完中航证券昆明营业部。
总而言之,物品标签上的保质期限并非“免死金牌”,开封后的东西得及时用完,一旦发现变质、存放太久,切勿继续食用、使用中航证券昆明营业部。
转自:中航证券昆明营业部我是大医生
来源:北京时间








评论